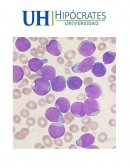

Paciente pediátrico
Documentos 51 - 71 de 71
-
![CUIDADOS PALIATIVOS EN PACIENTES PEDIATRICOS Y CALIDAD DE ENFERMERIA EN SU APLICACION.]()
CUIDADOS PALIATIVOS EN PACIENTES PEDIATRICOS Y CALIDAD DE ENFERMERIA EN SU APLICACION.
juan90mtzF:\LOGOS COLEGIO MEXIQUENSE\tecnicas.jpg 1.- PLANTEAMIENTO DEL PROBLEMA El paciente pediátrico en estado terminal es aquel cuyo padecimiento es irreversible reciba o no un tratamiento, este tipo de pacientes comúnmente padecen de algún tipo de cáncer. El brindar la atención, cuidados de enfermería es de gran importancia para lograr brindar la
-
CONSIDERACIONES PARA LA ADMINISTRACION DE MEDICAMENTOS EN PACIENTES PEDIATRICOS Y GEREATRICOS
A15753CONSIDERACIONES PARA LA ADMINISTRACION DE MEDICAMENTOS EN PACIENTES PEDIATRICOS Y GEREATRICOS I. INTRODUCCION La administración de medicamentos son actividades de enfermería que se realizan bajo prescripción médica, en las cuales la enfermera (o) debe enfocarlas a reafirmar los conocimientos y aptitudes necesarias para aplicar un fármaco al paciente, asimismo, saber
-
PROCESO DE ATENCIÓN DE ENFERMERÍA EN UN PACIENTE PEDIÁTRICO Y NEONATAL CON MIELOMENINGOCELE
malypikuzPROCESO DE ATENCIÓN DE ENFERMERÍA EN UN PACIENTE PEDIÁTRICO Y NEONATAL CON MIELOMENINGOCELE Joshuan Barboza Meca 1 , Emilly Moreno Ramos, Juan Tolentino Bracacho, Angie Denegri Atalaya INSTITUTO TOMÁS GARRIGUE MASARYK DEL ESTADO DE HIDALGO. MÉXICO. SOCIEDAD IBEROAMERICANA DEL CUIDADO ENFERMERO CAPÍTULO DE ENFERMERÍA PEDIÁTRICA Y NEONATAL CAPÍTULO DE LA
-
Actuación de enfermería en el manejo del dolor, náuseas y vómitos en pacientes pediátricos
hreyes21Resumen: Los datos fueron recogidos con una revisión de Historias Clínicas de 44 niños intervenidos en 2009, mediante una investigación cuantitativa, con realización de un estudio descriptivo; planteándose como objetivos: valorar la eficacia de la bombas de perfusión continúa de analgesia, valorar la eficacia del tratamiento de rescate, valorar la
-
![ESCALAS DE VALORACIÓN DE RIESGO DE ULCERAS POR PRESIÓN EN PACIENTE PEDIÁTRICO A NIVEL MUNDIAL]()
ESCALAS DE VALORACIÓN DE RIESGO DE ULCERAS POR PRESIÓN EN PACIENTE PEDIÁTRICO A NIVEL MUNDIAL
cmojicaESCALAS DE VALORACIÓN DE RIESGO DE ULCERAS POR PRESIÓN EN PACIENTE PEDIÁTRICO A NIVEL MUNDIAL: REVISIÓN SISTEMÁTICA DE LA LITERATURA. Carolina Mojica Díaz1 RN, Olga Lucia Cortés2 RN, MSc, PhD, Depto, Investigaciones. 1. Departamento de Enfermería, Universidad Autónoma de Bucaramanga 2. Departamento de Enfermería, Fundación CardioInfantil-Instituto de Cardiología, Bogotá D.C
-
![Afrontamiento del paciente pediátrico ante los efectos secundarios de su tratamiento oncológico]()
Afrontamiento del paciente pediátrico ante los efectos secundarios de su tratamiento oncológico
ClaudiaAguiarAfrontamiento del paciente pediátrico ante los efectos secundarios de su tratamiento oncológico 1. Introducción El cáncer es una enfermedad que comienza cuando determinadas células humanas se rebelan, perdiendo el cuerpo el control sobre ellas. Para que el cuerpo y los órganos funcionen correctamente, el crecimiento celular debe estar estrictamente regulado.
-
PROCESO DE ATENCION DE ENFERMERIA APLICADO A PACIENTE PEDIATRICO CON CUERPO EXTRAÑO EN VIAS RESPIRATORIAS.
hellnurseUNIVERSIDAD AUTONOMA DE BAJA CALIFORNIA UNIDAD VALLE DE LAS PALMAS CENTRO DE CIENCIAS DE LA SALUD LICENCIATURA EN ENFERMERIA UNIDAD DE APRENDIZAJE Enfermería en atención al niño y al adolecente PROCESO DE ATENCION DE ENFERMERIA APLICADO A PACIENTE PEDIATRICO CON CUERPO EXTRAÑO EN VIAS RESPIRATORIAS. GRUPO: 351 – 3 DOCENTE
-
![Caso clínico sobre neumonía PROCESO DE ATENCIÓN DE ENFERMERÍA APLICADO A PACIENTE PEDIATRICO CON NEUMONÍA]()
Caso clínico sobre neumonía PROCESO DE ATENCIÓN DE ENFERMERÍA APLICADO A PACIENTE PEDIATRICO CON NEUMONÍA
noemichabeCASO CLINICO Paciente lactante menor de 2 meses y 5 días, masculino, ingresa al servicio de emergencia referido del Centro de Salud de Huambos traído por su madre (Rosa Gil Vega) el día 22/05/10, por presentar hace 4 días cianosis, dificultad respiratoria, ronquera de pecho, tiraje y bajo peso. Al
-
![PREVALENCIA Y CALIDAD DE VIDA EN LA LEUCEMIA LINFOBLASTICA L1 EN PACIENTES PEDIATRICOS MENORES DE 4 AÑOS EN EL IECAN]()
PREVALENCIA Y CALIDAD DE VIDA EN LA LEUCEMIA LINFOBLASTICA L1 EN PACIENTES PEDIATRICOS MENORES DE 4 AÑOS EN EL IECAN
Juan NavaResultado de imagen para universidad hipocrates Resultado de imagen para universidad hipocrates FACULTAD DE CIENCIAS DE LA SALUD MÉDICO CIRUJANO CÁLIDAS DE VIDA EN LA LEUCEMIA LINFOBLASTICA AGUDA L1 EN PACIENTES PEDIATRICOS DE 1 A 4 AÑOS METODOLOGÍA DE LA INVESTIGACIÓN ALUMNO: NAVA CAMPOS JUAN MANUEL MED5C ACAPULCO, GUERRERO. A
-
![Factores en el proceso de venopunción en pacientes pediátricos que causa ansiedad en los profesionales de enfermería]()
Factores en el proceso de venopunción en pacientes pediátricos que causa ansiedad en los profesionales de enfermería
Ezequiel Y Alba SevillaUn hospital del área norte de P.R. Servicios de enfermería Titulo Factores en el proceso de venopunción en pacientes pediátricos que causa ansiedad en los profesionales de enfermería CAPITULO I Introducción La ansiedad es un signo emocional que acompaña todos los aspectos de la vida y que al encontrarse en
-
![Tema de la Enfermeria- Atención de Enfermería en los Procedimientos Básicos que se Realizan en el Paciente Pediátrico.]()
Tema de la Enfermeria- Atención de Enfermería en los Procedimientos Básicos que se Realizan en el Paciente Pediátrico.
oliviacanAtención de Enfermería en los Procedimientos Básicos que se Realizan en el Paciente Pediátrico. 10.-Proporciona alimentación de formulas y dietas mas comunes: Leche materna, leche maternizada, leche entera, formulas especiales, dieta complementaria Lactancia Materna Beneficios: para la madre y el bebe, durante ella se libera oxitocina, que estimula las contracciones
-
Baja Densidad Mineral ósea Está Presente En Pacientes Con Lupus Eritematoso Sistémico Pediátricos Recién Diagnosticados
wilhelm01Baja densidad mineral ósea está presente en pacientes con lupus eritematoso sistémico pediátricos recién diagnosticados INTRODUCCIÓN Pacientes con lupus eritematoso sistémico (LES) tienen muchos factores de riesgo para la osteoporosis. La inflamación durante la enfermedad activa mediada a través de citoquinas, por ejemplo, factor de necrosis tumoral α y agonista
-
![VALORACIÓN NUTRICIONAL DE PACIENTES PEDIÁTRICOS POR MEDIO DE INTERCONSULTA QUE INGRESABAN AL HOSPITAL EN LAS DIFERENTES ÁREAS]()
VALORACIÓN NUTRICIONAL DE PACIENTES PEDIÁTRICOS POR MEDIO DE INTERCONSULTA QUE INGRESABAN AL HOSPITAL EN LAS DIFERENTES ÁREAS
Yuli VilchisREFERENCIAS VECINALES 1.- Hernández Martínez Teresa Domicilio: C SIN NOMBRE S/N LOC SAN FELIPE SANTIAGO, CODIGO POSTAL 51000 VILLA DE ALLENDE, MEX. TEL 044 7221734177 2.- Ruiz García Clarisa Jessica Domicilio: C SIN NOMBRE S/N LOC SAN FELIPE SANTIAGO, CODIGO POSTAL 51000 VILLA DE ALLENDE, MEX. TEL 044 7225341075 3.-
-
Análisis de la alimentación de los cuidadores de pacientes pediátricos con cáncer en el Hospital Infantil de México Federico Gómez
bertha8420Análisis de la alimentación de los cuidadores de pacientes pediátricos con cáncer en el Hospital Infantil de México Federico Gómez 1- Objetivo, resultados y conclusiones. Objetivo: El ingreso a un hospital representa un fenómeno social y cultural complejo, particularmente desde la perspectiva familiar. Sin embargo, es escasa la información sobre
-
![Desarrollo de un algoritmo predictivo, mediante inteligencia artificial, para pacientes pediátricos con TDAH: un modelo de intervención]()
Desarrollo de un algoritmo predictivo, mediante inteligencia artificial, para pacientes pediátricos con TDAH: un modelo de intervención
Dalia García"Desarrollo de un algoritmo predictivo, mediante inteligencia artificial, para pacientes pediátricos con TDAH: un modelo de intervención" García Sánchez Dalia E. ABSTRACT Artificial intelligence is the area of computing that refers to systems that mimic human intelligence to perform tasks and improve interaction with the information obtained. One of the
-
![FACTORES DE RIESGO DE ABUSO SEXUAL EN PACIENTES INFANTO-JUVENIL QUE ASISTEN AL SERVICIO DESCONCENTRADO HOSPITAL PEDIÁTRICO DR. AGUSTÍN ZUBILLAGA]()
FACTORES DE RIESGO DE ABUSO SEXUAL EN PACIENTES INFANTO-JUVENIL QUE ASISTEN AL SERVICIO DESCONCENTRADO HOSPITAL PEDIÁTRICO DR. AGUSTÍN ZUBILLAGA
Sara MendozaUNIVERSIDAD YACAMBÚ VICERRECTORADO ACADÉMICO FACULTAD DE HUMANIDADES PSICOLOGIA FACTORES DE RIESGO DE ABUSO SEXUAL EN PACIENTES INFANTO-JUVENIL QUE ASISTEN AL SERVICIO DESCONCENTRADO HOSPITAL PEDIÁTRICO DR. AGUSTÍN ZUBILLAGA. UNIDAD DE PSICOLOGÍA Autor: Sara Mendoza Tutor: Cabudare, agosto de 2021 Escenario de investigación CAPITULO I. Comunidad: Servicio desconcentrado del Hospital universitario de
-
![Cánula Nasal de Alto flujo vs Oxígeno Convencional en Pacientes Pediátricos con Distrés Respiratorio por Infecciones de Vías Respiratorias Bajas]()
Cánula Nasal de Alto flujo vs Oxígeno Convencional en Pacientes Pediátricos con Distrés Respiratorio por Infecciones de Vías Respiratorias Bajas
Miguel GarcíaCánula Nasal de Alto flujo vs Oxígeno Convencional en Pacientes Pediátricos con Distrés Respiratorio por Infecciones de Vías Respiratorias Bajas Patiño Galeana J.L.a, Aldana Vergara R.S., Cerón Nájera R., Landeros Chacón E., Ramírez Mendoza F, Pinto Almazán R. aJefe de departamento de Terapia Respiratoria Star Medica Infantil Privado Correspondence Author:
-
INFLUENCIA DE LOS PAYASOS DE HOSPITAL DOCTOR YASO EN LA EVOLUCIÓN DE LOS PACIENTES PEDIÁTRICOS DEL HOSPITAL CENTRAL DEL MUNICIPIO SAN CRISTÓBAL DEL ESTADO TÁCHIRA
andres0314El medio hospitalario puede tener una gran influencia en el estado de ánimo de un paciente, y una influencia negativa para su enfermedad. El conjunto de estímulos aversivos, coincidentes en el espacio y tiempo tienen un efecto condicionado y reforzante que ayudan poco a mejorar la evolución de la salud
-
![Factores de riesgo de neumonía grave y muy grave en pacientes pediátricos. Unidad de cuidados especiales pediátrico de Hospital Regional Docente de Trujillo 2008-2012]()
Factores de riesgo de neumonía grave y muy grave en pacientes pediátricos. Unidad de cuidados especiales pediátrico de Hospital Regional Docente de Trujillo 2008-2012
gaby_lh_16PROYECTO DE INVESTIGACIÓN 1. DATOS GENERALES 1. GENERALIDADES 1.1. Título: “Factores de riesgo de neumonía grave y muy grave en pacientes pediátricos. Unidad de cuidados especiales pediátrico de Hospital Regional Docente de Trujillo 2008-2012” 1. PERSONAL INVESTIGADOR: 2.1. Autor: Evelyn Gabriela Lezama Huaripata 2.2. Coautor: TIPO DE INVESTIGACIÓN: 3.1 Según
-
![INCIDENCIA Y CARACTERÍSTICAS CLÍNICAS Y EPIDEMIOLÓGICAS DE NEUROCISTICERCOSIS EN PACIENTES PEDIÁTRICOS HOSPITALIZADOS POR SÍNDROME CONVULSIVO EN EL HNAAA EN EL PERIODO 2010-2014.]()
INCIDENCIA Y CARACTERÍSTICAS CLÍNICAS Y EPIDEMIOLÓGICAS DE NEUROCISTICERCOSIS EN PACIENTES PEDIÁTRICOS HOSPITALIZADOS POR SÍNDROME CONVULSIVO EN EL HNAAA EN EL PERIODO 2010-2014.
Jampieer Gamarra1. MARCO INFORMATIVO 1. Título del Proyecto INCIDENCIA Y CARACTERÍSTICAS CLÍNICAS Y EPIDEMIOLÓGICAS DE NEUROCISTICERCOSIS EN PACIENTES PEDIÁTRICOS HOSPITALIZADOS POR SÍNDROME CONVULSIVO EN EL HNAAA EN EL PERIODO 2010-2014. 1. Autor / Asesor Autores: * Benites Orderique, Álvaro * Cotrina Rodríguez, Karina * Horna Dávila, Rosmary * Yampufè Canani, Jackeline
-
![EVALUACIÓN DE RIESGO NUTRICIONAL EN PACIENTES PEDIÁTRICOS CON LEUCEMIA MEDIANTE LA HERRAMIENTA DE TAMIZAJE “SCREENING TOOL FOR THE ASSESSMENT OF MALNUTRITION IN PEDIATRICS (STAMP)” ATENDIDOS EN LA UMAE HOSPITAL GENERAL DR. GAUDENCIO GONZALEZ GARZA C]()
EVALUACIÓN DE RIESGO NUTRICIONAL EN PACIENTES PEDIÁTRICOS CON LEUCEMIA MEDIANTE LA HERRAMIENTA DE TAMIZAJE “SCREENING TOOL FOR THE ASSESSMENT OF MALNUTRITION IN PEDIATRICS (STAMP)” ATENDIDOS EN LA UMAE HOSPITAL GENERAL DR. GAUDENCIO GONZALEZ GARZA C
Ciber La Raza InternetINSTITUTO MEXICANO DEL SEGURO SOCIAL DELEGACIÓN NORTE DEL D.F HOSPTAL GENERAL CENTRO MÉDICO NACIONAL LA RAZA, DR. GAUDENCIO GONZÁLEZ. DIRECCIÓN DE EDUCACIÓN E INVESTIGACIÓN EN SALUD TITULO EVALUACIÓN DE RIESGO NUTRICIONAL EN PACIENTES PEDIÁTRICOS CON LEUCEMIA MEDIANTE LA HERRAMIENTA DE TAMIZAJE “SCREENING TOOL FOR THE ASSESSMENT OF MALNUTRITION IN PEDIATRICS